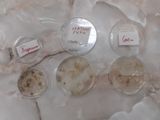

Администрация Рузаевского муниципального района Республики Мордовия
Муниципальное бюджетное учреждение дополнительного образования
"Центр дополнительного образования детей "ЮНИТЭР"
Рузаевского муниципального района
Адрес: 431449, Республика Мордовия, г. Рузаевка, Школьный бульвар, д. 1
Телефон: 8-834-51-2-58-52, 8-834-51-6-99-86
Мир бактерий.
В путешествие в мир бактерий отправились обучающиеся на занятии Т.О."Ботаника и зоология" (руководитель Воеводина Н.М.), открытого в рамках Национального проекта "Образование", Федерального проекта "Успех каждого ребёнка" по созданию новых мест для дополнительного образования детей. В ходе занятия воспитанники узнали, что такое микробы и бактерии, познакомились с их видами, строением, с их ролью в природе и жизни человека и мерами предупреждения заболеваний, вызываемыми бактериями.
Также ребята вместе с педагогом провели любопытный эксперимент, который помог им проверить много ли микроорганизмов в воздухе нашего кабинета, а также на других предметах. Приготовив питательную среду для выращивания микроорганизмов, залили её в чашечки Петри. С помощью ватных палочек собрали микробы с разных предметов, провели ими по поверхности питательной среды и закрыли крышечками. Оставили посевы в теплом и темном месте. Через несколько дней мы увидели интересные и ужасающие результаты эксперимента! Рассматривая колонии грибов и плесени, обучающиеся сделали выводы. Меньше всего плесени выросло на посеве микроорганизмов с телефона, ноутбука. А вот с поверхности крана, из воздуха попало много микробов.